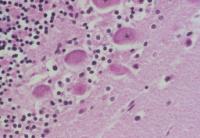
內基氏小體

簡介
內基氏小體
內基氏小體狂犬病毒形成的包涵體。
外形特徵
內基氏小體(Negri bodies)呈圓形或橢圓形,直徑約3~10nm,邊緣整齊,內有1~2個狀似細胞核的小點。
隱藏位置
最常見於海馬及小腦浦肯野組織的神經細胞中;亦可在大腦皮層的錐細胞層、脊髓神經細胞、后角神經節、視網膜神經細胞層、交感神經節等處檢出。內基氏小體實為病毒的集落,電鏡下可見小體內含有桿狀病毒顆粒。
相關資料
【狂犬病】
狂犬病俗稱瘋狗病,是由狂犬病病毒引起的一種人畜共患的急性接觸性傳染病。該病以神經調節高度障礙,表現狂躁不安和意識紊亂為特徵,最終發生麻痹而死。狂犬病病毒在動物體內主要存在於中樞神經(海馬角、大腦皮層、小腦等)細胞和唾液腺細胞內;可在胞漿內形成特異的包涵體——內基氏小體,在診斷上有重要意義。
[診斷要點]
流行特點 除羊外,犬、人和多種家畜及野生動物均有易感性;主要傳染源有患病的家犬及帶病毒的野生動物(如野犬、狼、狐等)。患病動物主要經唾液腺排毒,以咬傷為主要傳播途徑;也可經損傷的皮膚、黏膜傳染;另外,經呼吸道及口腔傳播業已得到證實。以散發性流行為主。
臨床症狀 狂犬病在臨床上分為狂暴型和沉鬱型兩種病型。狂暴型病畜初期精神沉鬱,反芻、食慾減少;不久表現起臥不安,出現興奮和衝擊動作,衝撞牆壁,磨牙流涎,性慾亢進,攻擊動物等,常舔咬傷口,使之經久不愈;末期發生麻痹,臥地不起,衰竭而死。沉鬱型病例多無興奮期或興奮期短,而且迅速轉入麻痹期,出現喉頭、下頜、後軀麻痹,流涎,張口、吞咽困難等症狀,最終臥地而死。剖檢變化 屍體無特異性變化;消瘦,有咬傷、裂傷,口腔和咽喉黏膜充血或糜爛;組織學檢查有非化膿性腦炎,可在神經細胞的胞漿內形成嗜酸性包涵體——內基氏小體。
實驗室檢查
1.內基氏小體檢查法 取大腦海馬角或小腦作觸片,用塞萊(seller)氏染色劑染色,鏡檢,內基氏小體呈櫻桃紅色。
2.螢光抗體法 取可疑病腦組織或唾液腺製成觸片或冰凍切片,用螢光抗體染色,置於螢光顯微鏡下觀察,胞漿內出現黃綠色螢光顆粒者為陽性。
3.血清學檢驗方法 常用中和試驗、補體結合試驗、血凝抑制試驗等血清學檢驗方法進行病毒鑑定、患病動物診斷及疫苗效果檢查等。
[類症鑑別]
狂犬病臨床診斷較為困難,常易與日本乙型腦炎、偽狂犬病等相混淆。鑑別診斷主要靠實驗室檢驗。人畜有咬傷病史時,對可疑病犬拘禁觀察或撲殺,取病料進行內基氏小體的檢查、病毒分離鑑定及血清學檢驗。
[防治措施]
治療 羊和家畜被患有狂犬病或可疑的動物咬傷時,應及時用清水或肥皂水沖洗傷口,再用0.1%升汞、碘酒或硝酸銀等處理傷口,並立即接種狂犬病疫苗;有條件時也可用免疫血清進行治療。對被狂犬咬傷的羊和家畜一般應予撲殺,以免危害於人。
預防
第一,撲殺野犬、病犬及拒不免疫的犬類。養犬必須登記註冊,進行免疫接種。
第二,疫區與受威脅區的羊和易感動物接種弱毒疫苗或滅能菌苗。
第三,加強國境檢疫,未接種疫苗的犬及易感動物進入時須隔離觀察6個月,並接種疫苗。
